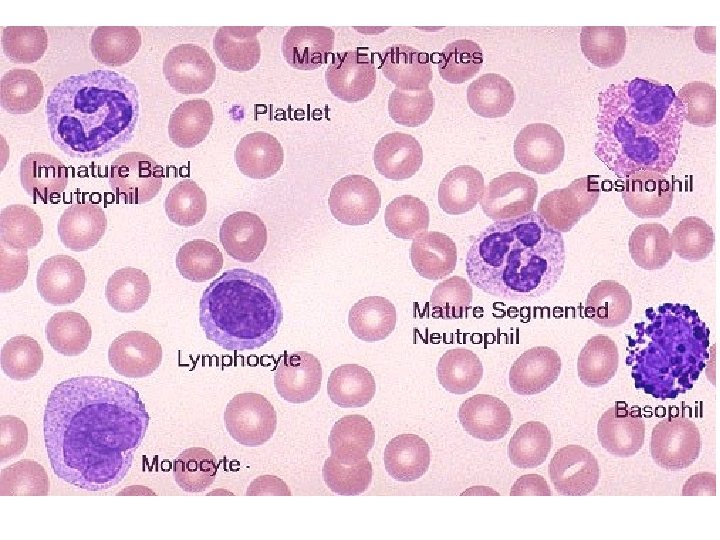

INFLAMMATION AND REPAIR Lecture 5 Tissue Repair and






















































- Slides: 54

INFLAMMATION AND REPAIR Lecture 5 Tissue Repair and Regeneration Foundation Block, pathology 2014 Dr. Maha Arafah Associate Professor Department of Pathology King Khalid University Hospital and King Saud University Email: marafah@ksu. edu. sa marafah @hotmail. com 1

Clinical Features The 5 ancient cardinal signs of inflammation are Tumor: -swelling Rubor : – redness Calor: – warmth Dolor : – pain Functio Laesa : – loss of function The suffix “its” is added to the base word to state the condition as in appendix/appendicitis

Inflammation is divided into: Acute inflammation: • Immediate and early response to tissue injury (physical, chemical, microbiologic, etc. ) • Acute inflammation has three major components: • Vasodilatation • Vascular leakage and edema • Leukocyte emigration (mostly PMNs) Chronic inflammation: • Inflammation of prolonged duration (weeks to years) in which continuing inflammation, tissue injury, and healing, often by fibrosis, proceed simultaneously

“clock face” pattern of nuclear chromatin with perinuclear halo

Vascular reaction:

Margination: movement of leukocyte to periphery Chemical mediators of. CD 31 the Activation of Chemotaxis: C 5 a. acute inflammatory response endothlium and Leukotriene B 4 leukocyte to express selectin by IL 1 and TNF Chemokines IL-1, TNF Bacterial products

Oxygen dependent and Oxygen independent killing occur in macrophages and neutrophils

Chemical Mediators

Prostaglandin are capable of causing pain, fever, chemotaxis and vasodilatation during the inflammatory process

Cytokine of Acute inflammation: Interleukin (IL-1) & TNF

Role of Mediators in Different Reactions of Inflammation Vasodilation Prostaglandins Histamine Nitric oxide Increased vascular permeability Vasoactive amines Bradykinin Leukotrienes C 4, D 4, E 4 PAF Substance P Chemotaxis, leukocyte recruitment and activation C 5 a Leukotriene B 4 Chemokines IL-1, TNF Bacterial products Fever IL-1, TNF Prostaglandins Pain Prostaglandins Bradykinin Tissue damage Neutrophil and macrophage lysosomal enzymes Oxygen metabolites Nitric oxide

13

Cytokines of Chronic Inflammation: Interferon-γ (INF- γ) & Interleukin ( IL-12) Activated lymphocytes and macrophages influence each other and also release inflammatory mediators that affect other cells.

Systemic effects of Inflammation • Acute phase reaction/response IL-1 and TNF Fever Malaise Anorexia • Bone marrow leukocytosis IL-1 + TNF • Lymphoid organs • Liver -IL-6, IL-1, TNF -Acute phase proteins – C-reactive protein – Lipopolysaccharide binding protein – Serum amyloid A – a-2 macroglobulin – Haptoglobin – Ceruloplasmin – fibrinogen

Fever • In the hypothalamus, the prostaglandins, especially PGE 2, stimulate the production of neurotransmitters such as cyclic AMP, which function to reset the temperature set-point at a higher level. • NSAIDs, including aspirin , reduce fever by inhibiting cyclooxygenase and thus blocking prostaglandin synthesis.

Increased erythrocyte sedimentation rate • The rise in fibrinogen causes erythrocytes to form stacks (rouleaux) that sediment more rapidly at unit gravity than do individual erythrocytes.

Objectives Upon completion of this lecture, the student should: 1. 2. 3. 4. 5. 6. 18 Describe the differences between the various cell types (ie, labile, stable, and permanent cells) in terms of their regeneration potential. List examples of each cell type. Know the factors that are most important in determining whether regeneration will restore normal tissue architecture. List the three main phases of cutaneous wound healing. Compare and contrast the difference between healing by primary intention and healing by secondary intention. List factors which are associated with delayed wound healing. List complication of wound healing.

Goal of the repair process �To restore the tissue to its original state after inflammatory reaction Some tissues can be completely reconstituted after injury, such as the repair of bone after a fracture or the regeneration of the surface epithelium in a cutaneous wound. For tissues that are incapable of regeneration, repair is accomplished by connective tissue deposition, producing a scar.


If damage persists, inflammation becomes chronic, and tissue damage and repair may occur concurrently. Connective tissue deposition in these conditions is usually referred to as fibrosis.


Repair by tissue regeneration or healing depend on cell type. • Labile cells: continue to proliferate throughout life : squamous, columnar, transitional epithelia; hematopoitic and lymphoid tissues • Stable cells: retain the capacity of proliferation but they don’t replicate normally: parenchymal cells of all glandular organs & mesenchymal cells • Permanent cells: cannot reproduce themselves after birth: neurons, cardiac muscle cells



Healing • Healing is usually a tissue response (1) to a wound (commonly in the skin) (2) to inflammatory processes in internal organs (3) to cell necrosis in organs incapable of regeneration


Mechanism of repair • Repair begins early in inflammation. • At site of inflammation, fibroblasts and vascular endothelial cells begin proliferating to form a specialized type of tissue (hallmark of healing) called: granulation tissue • The process is called organization

© 2005 Elsevier

Repair by connective tissue (granulation tissue) • It consists of: 1. fibroblasts surrounded by abundant extracellular matrix 2. newly formed blood vessels 3. scattered macrophages and some other inflammatory cells.

What is the role of macrophages in wound healing? • Cleanup of debris, fibrin, and other foreign material at the site of repair. • Macrophages recruit other cells: fibroblasts and angioblasts • Stimulation of matrix production , interleukins that stimulate fibroblasts and angioblasts to produce the extracellular matrix. • Remodeling of the scar. They secrete collagenases

Role of macrophages in wound healing

Fibroblast Migration and Proliferation �Migration of fibroblasts to the site of injury and their subsequent proliferation are triggered by multiple growth factors, including mainly TGF-β and others e. g. PDGF, EGF, FGF, and the cytokines IL-1 and TNF �This lead to: 1. increased synthesis of collagen and fibronectin 2. decreased degradation of extracellular matrix (ECM) by metalloproteinases �

ECM Deposition and Scar Formation �As repair continues, the number of proliferating endothelial cells and fibroblasts decreases. �Net collagen accumulation, however, depends not only on increased collagen synthesis but also on decreased degradation.

Granulation tissue morphology As early as 24 hr. after injury, fibroblasts and vascular endothelial cells begin proliferating to form (by 3 -5 days) granulation tissue - pink soft granular appearance on the surface of the wound. New granulation tissue is often edematous. • histologically : granulation tissue is composed of : • proliferation of new small blood vessels and • proliferation of fibroblasts • macrophags

Angiogenesis from Endothelial Precursor Cells

SCAR FORMATION • Further healing: increased collagen, decreased active fibroblasts and new vessels(thrombosis and degeneration) • At the end: scar (inactive fibroblasts, dense collagen, fragments of elastic tissue, extracellular matrix, few vessels).

Slide 4. 19 W. B. Saunders Company items and derived items Copyright (c) 1999 by W. B. Saunders Company

Functions of the Extracellular Matrix • The ECM is much more than a space filler around cells. Its various functions: – Mechanical support – Control of cell proliferation – Scaffolding for tissue renewal – Establishment of tissue microenvironments.


Cutaneous Wound healing 1. Primary union (healing by 1 st intention) • clean surgical incision • no significant bacterial contamination • minimal loss of tissue • clot, scab formation 2. Secondary union (healing by 2 nd intention) • more extensive loss of cells and tissue: -infarction -inflammatory ulceration -abscess formation • surface wound with large defect • large tissue defect that must be filled

Primary union (healing by first intention) 24 hr. : hematoma & neutrophils, mitotic activity of basal layer, thin epithelial layer Hageman factor (factor 12) will activate both the coagulation sequence and the kinin system as an initial response to this injury day 3: macrophages, granulation tissue day 5: collagen bridges the incision, epidermis thickens 2 nd week: : continued collagen and fibroblasts, blanching End of 1 st month: scar (cellular connective tissue, intact epidermis, lost appendages).

Primary union (healing by first intention) • Later, collagen type III is slowly replaced by collagen type I and the wound acquires tensile strength. • By the end of third month, the tissue has approximately 80% of its original strength.


Cutaneous Wound healing Secondary union (healing by 2 nd intention) It occur in large, gaping wounds, as well those that are infected or contain foreign material

Difference between primary intention and secondary intention • The basic process of healing is the same in all wounds. In contrast to healing by primary intention, wounds healing by secondary intention – Require more time to close because the edges are far apart – Show a more prominent inflammatory reaction in and around the wound – Contain more copious granulation tissue inside the tissue defect – wound contraction (5 to 10%), ? myofibroblasts

Mechanisms of fibrosis • Persistent tissue injury leads to chronic inflammation and loss of tissue architecture. • Cytokines produced by macrophages and other leukocytes stimulate the migration and proliferation of fibroblasts and myofibroblasts and the deposition of collagen and other extracellular matrix proteins. • The net result is replacement of normal tissue by fibrosis.

Delayed wound healing

What is the most common cause of delayed wound healing? • • • Infection Foreign bodies in the wound Suture help healing of wound Mechanical factors protein deficiency and vitamin C Nutritional deficiencies deficiency inhibit collagen synthesis and retard healing. Zinc and copper deficiency Poor perfusion the most important cause of delay in healing; it prolongs inflammation and potentially increases the local tissue injury. due either to arteriosclerosis and diabetes or to obstructed venous drainage • Excess corticosteroid

Excess corticosteroid • have well-documented anti-inflammatory effects, and their administration may result in weakness of the scar • however, the anti-inflammatory effects of glucocorticoids are sometime desirable. For example, in corneal infections

COMPLICATIONS IN CUTANEOUS WOUND HEALING • Complications in wound healing can arise from abnormalities in any of the basic components of the repair process. These aberrations can be grouped into three general categories: – (1) deficient scar formation – (2) excessive formation of the repair components – (3) formation of contractures.

Wound dehiscence Keloid Wound ulceration Contracture

What is a keloid? • Keloids are excessive scars composed of irregularly deposite hyalinized collagen bands. They may appear as bulging masses.

TAKE HOME MESSAGES: • The various cell types (ie, labile, stable, and permanent cells) affect the outcome of healing. • Three main phases of cutaneous wound healing: – (1) inflammation, (2) formation of granulation tissue, and (3) ECM deposition and remodeling • Healing by primary intention occur in surgical clean wound and healing by secondary intention occur when excessive tissue damage is present. • Several factors are associated with delayed wound healing. • Complication of wound healing include failure of healing, contracture and excessive scar formation.